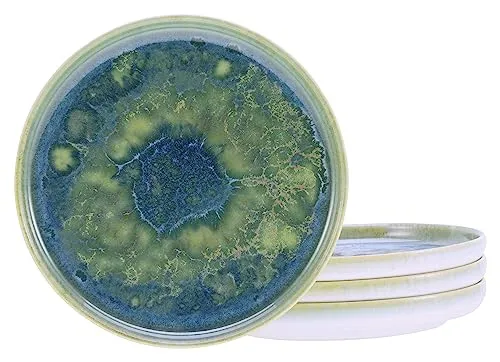
CreaTable Yuki 4-teiliges Geschirrset, mehrfarbig,CreaTable

CreaTable Geschirr Blau
Aktuelle Angebote 2026: CreaTable Geschirr Blau im Preisvergleich




CreaTable Serie Nature Collection Water 4-teiliges Geschirrset
6 Angebote vergleichen
28,31 €
28,31 €







CreaTable 20964 NATURE COLLECTION MEDITERRAN 12-teiliges Geschirrset
6 Angebote vergleichen
84,95 €
84,95 €

CreaTable Nature Collection Water, 16-teiliges Geschirrset für 4 Personen
6 Angebote vergleichen
80,33 €
84,72 €

Creatable Kombiservice 16-tlg. NATURE COLLECTION AQUA
7 Angebote vergleichen
78,32 €
82,00 €










CreaTable Pastateller Vintage Nature – 4-tlg. handgemalte Pastateller, 27 cm
6 Angebote vergleichen
54,03 €
58,97 €


Creatable Vintage Nature Aqua Pizzateller Set, 4-teilig
8 Angebote vergleichen
59,13 €
59,13 €

CreaTable 25857 Caldera Eisblau, 8-teiliges Geschirrset
8 Angebote vergleichen
42,95 €
42,95 €


CreaTable 25862 Serie Caldera Blau, 8-teiliges Geschirrset
7 Angebote vergleichen
42,95 €
42,95 €

CreaTable 23844 Serie Reactive Aqua, 16-teiliges Geschirrset
6 Angebote vergleichen
49,90 €
49,90 €

CreaTable 23845 Serie Reactive Aqua 12-teiliges Geschirrset
6 Angebote vergleichen
42,89 €
49,90 €


Creatable Schüsselset Mallorca, 4-teilig, handbemalt
9 Angebote vergleichen
34,32 €
34,32 €



CreaTable Kombiservice Geschirr-Set Mallorca (16-tlg) für 4 Personen
7 Angebote vergleichen
75,99 €
94,99 €




CreaTable 17406 Serie Folklore Blau, 16-teiliges Geschirrset
7 Angebote vergleichen
72,90 €
72,90 €


–13%
Wir arbeiten unabhängig und neutral. Wenn Sie auf ein verlinktes Shop-Angebot klicken, unterstützen Sie uns dabei. Wir erhalten dann ggf. eine Vergütung. Mehr erfahren
Verwandte Suchen
GeschirrCreaTable GeschirrGeschirr BlauCreaTable Geschirr WeißCreaTable Geschirr SchwarzThomas Geschirr BlauRosenthal Geschirr BlauASA Geschirr BlauCreaTable Geschirr GrünCreaTable Geschirr GrauCreaTable Geschirr BeigeSeltmann Weiden Geschirr BlauGreenGate Geschirr BlauSänger Geschirr BlauKahla Geschirr BlauRitzenhoff & Breker Geschirr BlauBloomingville Geschirr BlauPip Studio Geschirr BlauBitz Geschirr BlauLEONARDO Geschirr Blau